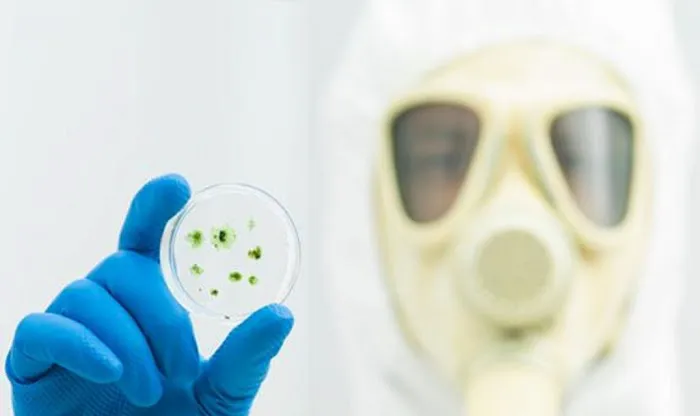
Simply Mold Gone Picture 2
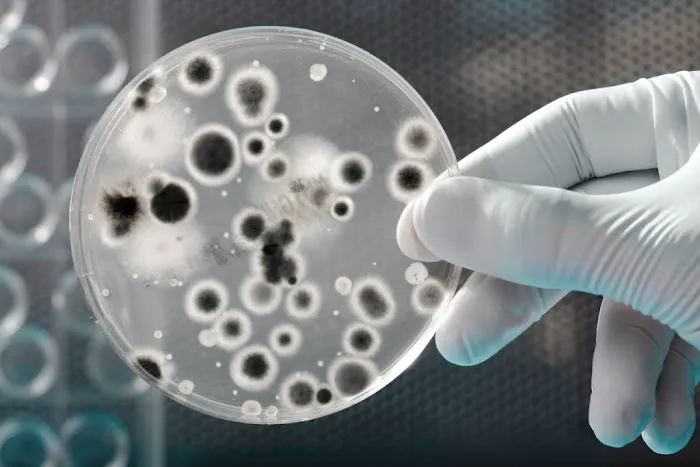
Simply Mold Gone Picture 6

Simply Mold Gone Photos

Simply Mold Gone Introduce
For homeowners and commercial property managers throughout the greater Chicago and Illinois region, the presence of mold is more than just an aesthetic issue—it's a critical environmental, health, and structural problem. Addressing this complex challenge requires a dedicated specialist who functions as a fully capable general contractor in the field of disaster restoration. This is the precise role of Simply Mold Gone. As a trusted, Chicago-based company, Simply Mold Gone has carved out a niche as the premier specialized general contractor for comprehensive Mold Remediation Chicago and essential Water Damage Restoration Service.
Their approach is thorough and science-based, rooted in the understanding that where there is mold, there is a water problem that needs fixing. Unlike standard cleaning services, Simply Mold Gone provides an end-to-end solution. They start with accurate diagnostics, move through safe and complete mold removal, and ultimately offer the necessary restoration and reconstruction work to return your property to its original, healthy condition. This full-service commitment ensures that Illinois clients receive not only a mold-free environment but also the assurance that the underlying moisture source is mitigated, providing genuine, long-term mold prevention Chicago.
Their focus is on turning a stressful situation—such as discovering Black Mold Removal Chicago is necessary, or dealing with the aftermath of water damage—into a smooth and professionally managed restoration project. This dedication to expertise and client care has earned them a reputation for being simply fantastic, as noted by long-time customers who rely on them for professional and efficient resolution every time an issue arises.
Simply Mold Gone is strategically positioned to serve the high-demand residential and commercial areas across Chicago and its suburbs. Their location in the city’s Northwest Side allows for efficient deployment to a wide service area, reaching clients quickly when time is of the essence in a water damage or mold emergency.
The primary office and operations base is located at:
3521 N Oconto Ave, Chicago, IL 60634, USA
The emphasis on rapid, Onsite services is a hallmark of their operation, understanding that prompt action is key to minimizing damage and reducing remediation costs. Whether you are searching for Mold Specialist Near Me Chicago or Mold Mitigation Near Me Chicago, their central location and operational readiness ensure that help is close at hand. This accessibility is vital for addressing time-sensitive issues like sudden leaks or discovering extensive mold growth in an Attic Mold Removal Chicago project.
Simply Mold Gone offers a complete spectrum of services to handle every facet of the mold and water damage restoration process. Their comprehensive list of offerings highlights their specialization and readiness to tackle any situation in an Illinois property:
- Mold Inspection and Testing: Services include Mold Inspection Chicago, Mold Testing Chicago, and Mold Inspection and Testing Chicago to accurately diagnose the problem, often finding hidden Black Mold Removal Chicago is needed.
- Core Mold Remediation and Removal: Expertise in Mold Remediation Chicago and Mold Removal Chicago, utilizing a professional Mold Cleaner Chicago to safely eliminate microbial growth from all surfaces.
- Targeted Area Remediation: Specialized services focusing on common problem areas in Illinois homes, such as Basement Mold Removal Chicago, Attic Mold Removal Chicago, Bathroom Mold Removal Chicago, and Shower Mold Removal Chicago.
- Water Damage Restoration: Providing essential Water Damage Restoration Service to address the initial cause of the mold, including drying, dehumidification, and structural preparation for reconstruction.
- Post-Remediation Treatment: The application of Mold Treatment Chicago and Mold Mitigation Chicago techniques, combined with Mold Prevention Chicago strategies, to ensure long-term protection.
- Materials Cleaning and Cleanup: Professional Materials Cleaning and comprehensive Mold Cleanup Chicago services to restore contaminated belongings and structural components.
- Project Management: Functioning as a full-scope Mold Removal Company Chicago, managing the entire project from initial inspection through to final cleanup, offering a hassle-free experience for the client.
Simply Mold Gone is worth choosing for Chicago and Illinois residents because of their commitment to expert specialization and client satisfaction. They have established several operational highlights that set them apart in the restoration industry:
- True Specialization: They are not a jack-of-all-trades; their brand is dedicated to being a premier Mold Specialist Near Me Chicago, ensuring their team is highly knowledgeable about the science and safe practices of mold mitigation.
- End-to-End Service: The firm operates as a complete Mold Removal Company Near Me Chicago, covering the entire process from Mold Inspection Near Me Chicago to the final mold remediation. This seamless transition minimizes client stress and project downtime.
- Proven Customer Satisfaction: Real customer reviews consistently praise the team for their 'Quick response and excellent work,' noting the professional and efficient manner in which they resolve issues, even making difficult jobs like two moldy showers look 'amazing and so clean.'
- Local Expertise for Local Issues: Their extensive experience in the Chicagoland area means they are intimately familiar with common local issues, such as moisture problems in older Chicago basements and attics, providing tailored and effective solutions.
- Professionalism and Efficiency: Customers frequently highlight the courtesy, knowledge, and professionalism of the staff, emphasizing that their work is quick, thorough, and completely explained, making a stressful situation feel manageable.
For residents and businesses in Illinois needing professional mold or water damage assistance, prompt communication is essential. Simply Mold Gone maintains open lines of contact for immediate service inquiries and scheduled appointments.
Address: 3521 N Oconto Ave, Chicago, IL 60634, USA
Primary Phone: (773) 502-4372
Mobile Phone: +1 773-502-4372
Their professional team is ready to provide a thorough inspection and begin the necessary process to restore the health and integrity of your property.
In the Illinois property market, especially in the older homes and humid conditions of Chicago, the risk of hidden mold is a constant concern. What is worth choosing Simply Mold Gone is their unparalleled commitment to a specialized, science-based, and client-friendly process. When you select a Mold Removal Company Near Me Chicago, you need assurance that the problem will not simply return, and Simply Mold Gone delivers this through their holistic service model.
The combination of highly specialized Mold Inspection and Testing Chicago and guaranteed Mold Remediation Near Me Chicago results in a level of confidence that generic general contractors cannot match. By addressing everything from the initial Water Damage Restoration Service to the final Mold Treatment Chicago, they embody the most valuable type of general contractor: one who provides a single, trusted source for resolving a crisis. Their positive reviews, which speak to the professionalism of their team members like Robert and Max, further confirm that they are not just focused on the technical removal but on the entire customer experience. For a permanent and stress-free solution to any mold or water damage issue in Illinois, choosing Simply Mold Gone is choosing peace of mind.
Simply Mold Gone Services
Water Damage Restoration Service
- Black Mold Removal Chicago
Black Mold Removal: Black Mold Removal targets the safe elimination of toxic black mold, ensuring your property is free from this harmful contaminant. Our specialized approach guarantees the health and safety of your space.
- Materials Cleaning
- Mold Cleaner Chicago
Our mold cleaner Chicago service is designed to remove mold effectively, giving you a safer and healthier space to enjoy.
- Mold Cleaner Near Me Chicago
If you’re looking for a trusted mold cleaner near me Chicago, we offer thorough and dependable cleaning to get rid of mold for good.
- Mold Cleaning Services Chicago
Our Mold Cleaning Services entail the deep cleaning and sanitization of areas affected by mold. Using safe and effective cleaning agents, we restore the cleanliness and safety of your property.
- Mold Inspection
- Mold Inspection Chicago
Our Mold Inspection Chicago service provides a thorough examination of your property to identify potential mold issues. With a keen eye for detail, our experts assess mold-prone areas, ensuring your home or business remains mold-free and healthy.
- Mold Inspection Near Me Chicago
Offering Mold Inspection near me services, we're ready to assess your property for mold with a detailed and professional approach, ensuring your living or working space is mold-free.
- Mold Inspection and Testing Chicago
Combining both mold inspection and testing, this service offers a thorough assessment of your property's mold situation. It's an all-encompassing approach to understanding and addressing mold issues.
- Mold Mitigation Chicago
Mold Mitigation focuses on reducing mold levels to safe amounts, employing strategic methods to control and prevent mold growth, thereby minimizing its health risks and structural damage to your property.
- Mold Mitigation Near Me Chicago
With Mold Mitigation near me Chicago service, we focus on reducing mold to safe levels and preventing its future growth, protecting your property and health.
- Mold Remediation Chicago
Mold Remediation Chicago specializes in addressing and correcting mold problems, employing industry-leading techniques to remove mold and prevent its return. Our team works diligently to restore the air quality of your space, making it safe for everyone.
- Mold Remediation Near Me Chicago
Our Mold Remediation near me Chicago services are designed to effectively tackle and resolve mold issues, restoring your property's air quality and ensuring a safe environment.
- Mold Removal Chicago
Our Mold Removal Chicago service is dedicated to efficiently eliminating mold from your property, ensuring a safe and healthy environment for you and your family. Utilizing advanced techniques and equipment, we target mold at its source, providing long-lasting solutions.
- Mold Removal Companies Chicago
As one of the top mold removal companies Chicago, we use advanced methods to eliminate mold and keep it from coming back.
- Mold Removal Companies Near Me Chicago
When searching for mold removal companies near me Chicago, choose us for our expert approach and commitment to long-term mold prevention.
- Mold Removal Company Chicago
Our mold removal company Chicago provides reliable solutions to tackle mold issues, ensuring a clean and safe environment for your property.
- Mold Removal Company Near Me Chicago
As your Mold Removal Company near me Chicago, we're committed to providing prompt and efficient mold elimination services, ensuring your property is safe and mold-free.
- Mold Specialist Near Me Chicago
Connect with a Mold Specialist near me Chicago, offering expert advice and services for all your mold-related concerns. Our specialists are equipped to handle any mold situation, providing peace of mind.
- Mold Testing Chicago
Mold Testing Chicago offers comprehensive mold detection services, using state-of-the-art tools to identify the presence and types of mold within your property. This service is crucial for understanding the extent of a mold issue and formulating an effective remediation plan.
- Mold Testing Near Me Chicago
With our local Mold Testing near me Chicago services, we provide quick and accurate mold detection, helping you understand the extent of your mold issue and the steps necessary for remediation.
- Mold Treatment Chicago
Mold Treatment involves a comprehensive approach to not only remove existing mold but also prevent its future growth. Through effective treatment methods, we safeguard your property against mold's harmful effects.
- attic mold removal Chicago
Attic mold removal services professionally eliminate harmful fungal growths in your attic, safeguarding your home's structural integrity and improving indoor air quality for healthier living.
- basement mold removal Chicago
Basement mold removal Chicago is a dedicated service that detects, eliminates, and prevents mold proliferation in basements, employing proven techniques and equipment to ensure a healthy and mold-free environment.
- bathroom mold removal Chicago
Bathroom mold removal Chicago service targets the safe and efficient eradication of mold in bathrooms, preventing its recurrence and ensuring a healthy and hygienic environment.
- mold cleanup Chicago
Mold cleanup is a comprehensive service provided by experts, dedicated to finding, removing, and preventing mold using environmentally friendly methods, thereby safeguarding health and maintaining structural integrity.
- mold inspection
Mold inspection is a professional service that assesses indoor spaces for mold growth, identifying potential sources and providing recommendations for remediation.
- mold prevention Chicago
Mold prevention Chicago service involves implementing measures to control moisture levels, improve ventilation, and apply protective coatings to surfaces, effectively minimizing conditions conducive to mold growth in indoor environments.
- mold remediation
Mold remediation is the process of safely removing and mitigating mold contamination in buildings to restore a healthy indoor environment and prevent further spread.
- mold removal
Mold removal is a specialized service focused on eliminating mold colonies from surfaces and materials to improve indoor air quality and prevent health issues caused by mold exposure.
- mold testing
Mold testing is a methodical examination of indoor air quality and surfaces to identify the presence of mold, determine its type, and assess potential health concerns.
- shower mold removal Chicago
Shower mold removal Chicago service targets the thorough elimination of mold and mildew in shower areas, including tiles, grout, and fixtures, to maintain a hygienic and mold-free bathing space.
Simply Mold Gone Details
Service options
- Onsite services
Simply Mold Gone Location
Simply Mold Gone
3521 N Oconto Ave, Chicago, IL 60634, USA
Simply Mold Gone Reviews
mold remediationhomecontractormold removalbasementreport
★ 5★ 4★ 3★ 2★ 1The Simply Mold guys (Robert and Max) are simply fantastic. I wish I didn't have to use them so much, but every time I have an issue they quickly resolve it in a professional and efficient manner. Highly recommend!
Jul 09, 2025 · Darius PoolQuick response and excellent work. We had mold in 2 showers, and afterwards they look amazing and so clean. Highly recommend.
Jul 14, 2025 · Kel LowndesRecently had a mold inspection, and the process was smooth and stress-free. The technician was efficient and explained each step. I'm glad I chose them for the job.
Apr 11, 2025 · Thelmy MaldonadoThe mold inspection was detailed and professional. The team found hidden spots I hadn't noticed and explained everything clearly. Highly recommend their service
Jan 09, 2025 · Carlos GarciaThey did a great job restoring my damaged wall and floors!
Jul 22, 2025 · Alok Vaidya
More Water Damage Restoration Near Me
Magdan Construction Inc5.0 (550 reviews)8450 W Grand Ave, River Grove, IL 60171, USA
Safer Restoration5.0 (6 reviews)3153 N Long Ave, Chicago, IL 60641, USA
Garden4.0 (14 reviews)6554 W Higgins Ave, Chicago, IL 60656, USA
Restore Construction4.0 (310 reviews)2035 N 15th Ave, Melrose Park, IL 60160, USA
Home Doctor Restoration4.0 (44 reviews)9447 Kelvin Ln, Schiller Park, IL 60176, USA
Intex Restoration5.0 (3 reviews)5844 N Moody Ave, Chicago, IL 60646, USA
ServiceMaster of Oak Park & River Forest0.0 (0 reviews)1010 Lake St #200, Oak Park, IL 60301, USA
Chicago Water & Fire Restoration4.0 (8 reviews)3964 N Avondale Ave, Chicago, IL 60641, USA
Chicagoland4.0 (24 reviews)10740 Grand Ave B, Franklin Park, IL 60131, USA
McKinley Co. | Chicago Roof Repair - Property Restoration - Public Adjuster3.0 (14 reviews)10929 Franklin Ave Suite O, Franklin Park, IL 60131, USA
AW Water Damage Restoration5.0 (32 reviews)8 Main St, Park Ridge, IL 60068, USA
Soluna5.0 (3 reviews)1540 N Mannheim Rd, Stone Park, IL 60165, USA
Categories
Top Visited Sites
Restoration 1 of Birmingham5.0 (285 reviews)
Enviro Clean Abatement4.0 (70 reviews)
Keystone Mitigation Services4.0 (142 reviews)
SERVPRO of Downtown Nashville/Team Bisig5.0 (5 reviews)
Faithfully Maid4.0 (36 reviews)
1-800-BoardUp of Philadelphia0.0 (0 reviews)Top Water Damage Restoration Searches
Trending Damage Repair Guides Posts
Water Damage Restoration for Retail Spaces – Expert Tips and Real Cases
How to Prevent Mold Growth After Water Damage in Your Basement
Water Damage Restoration for Apartments and Condos: Key Insights and Process
How to Handle Water Damage From Laundry Rooms | Reliable Damage Hub
Essential Tools for Water Damage Restoration at Home
The Hidden Dangers of Water Damage and How to Avoid Them
